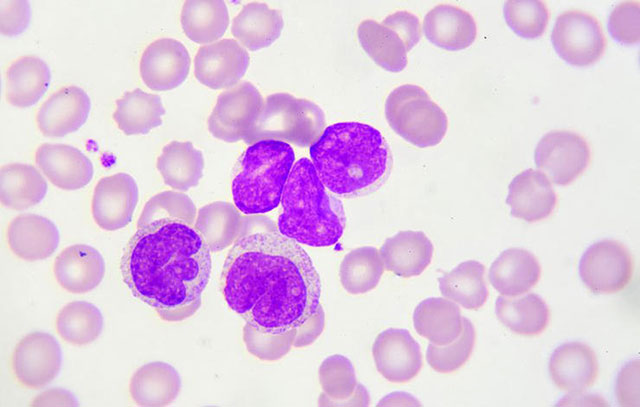
一觉醒来浑身是汗应该怎么调理,一觉醒来一身汗是咋回事

出汗是非常正常的生理现象。但如果卧室温度适宜、睡觉的活动量又不大,然后一觉醒来发现浑身是汗,甚至汗水已经将枕头和被单全部浸湿,就不免有些困惑和烦恼。民间一般将这种情况称为“盗汗”,多由“肾阴虚”所致。
但美国费城的家庭医生Rob Danoff却表示,现代医学(西医)既没有盗汗的概念,也根本不存在所谓的肾虚或者肾亏。
他指出,每个人都会偶尔醒来后感觉有些过热或者出汗,或者由于天气炎热,或者是因为被子过厚,都属于正常现象。
但如果是像之前所提到的非常严重的夜间出汗——譬如浸透床单或睡衣,就必须要引起重视了,这可能某些身体变化甚至疾病的征兆,包括以下5种:
1.女性围绝经期
根据世界卫生组织的定义,女性的围绝经期(俗称“更年期”)是指从出现与绝经有关的内分泌、生物学和临床特征起,至最后一次月经后一年的这一段时间(一般发生于45-55岁之间)。由于激素分泌发生变化,因此大量出汗是这一时期的典型现象。
《人类生物学刊》上刊登的一项研究发现,36%的围绝经期女性报告有夜间大量出汗的现象发生。而《更年期》杂志上的另一项研究则指出,有每天饮酒或酗酒习惯的女性,夜间大量出汗的发生率更高。
2.心血管疾病
《国际妇产科杂志》的一项2014年的研究发现,夜间频繁大量出汗的女性心血管疾病的患病风险更高。而除此之外超重肥胖、高血压和糖尿病也是女性“夜汗”的重要诱发因素。
3.甲状腺机能亢进

Danoff医生指出,多汗是甲状腺机能亢进(简称“甲亢”)的常见症状之一。其他一些与激素有关的疾病——比如肾上腺皮质功能减退,也可能导致夜间大量出汗。
4.感染或自身免疫性疾病
Danoff认为,通常机体的免疫系统在成功击退细菌或病毒感染,且其他疾病相关症状全部消失以后,患者还会经历短则数天,长可至数周的夜间出汗过程,这是免疫系统对抗感染的正常反应。
自身免疫性疾病则指由于免疫系统懵圈,错误地将身体正常组织当作敌人攻击而产生的疾病,比如系统性红斑狼疮和类风湿关节炎,这类疾病同样也可引发夜间大量出汗。
5.癌症
Danoff提醒到,某些癌症也可导致夜间出汗,最常见的包括霍奇金淋巴瘤和非霍奇金淋巴瘤。如果夜间大量出汗的同时还有不明原因消瘦、疲劳和淋巴结肿大,可能是癌症的征兆,建议立即就医。
Via:prevention.com
原标题:7 Things Your Night Sweats Are Trying To Tell You
原作者:Markham Heid
翻译:大苏
版权声明:本文为春雨医生原创稿件,版权归属春雨医生所有,未经授权禁止转载,授权与合作事宜请联系reading@chunyu.me